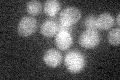
YKL117W
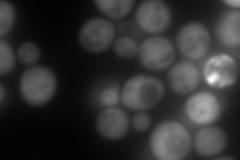
YKL117W
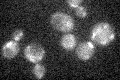
YKL117W

View description
Co-chaperone that binds to and regulates Hsp90 family chaperones; important for pp60v-src activity in yeast; homologous to the mammalian p23 proteins and like p23 can regulate telomerase activity
Localization:
Intensity:
Fold change:
Significance:
-
C’ GFP library in SD
below threshold17.6 -
N' NOP1pr-GFP in SD

cytosol386.607 -
N' TEF2pr-mCherry in SD
cytosol503.672 -
N' NATIVEpr-GFP in SD

cytosol168.888 -
N' TEF2pr-VC and Cyto-VN in SD

#N/A0 -
C’ GFP library in SD+DTT

cytosol18.341.04No -
C’ GFP library in SD+H2O2
cytosol14.310.81No -
C’ GFP library in Starvation Media

cytosol21.551.22No -
C’ GFP library on the background of Pup2-DaMP

below threshold -
C’ GFP library on the background of CCT mutant

below threshold15.57610.884591No
